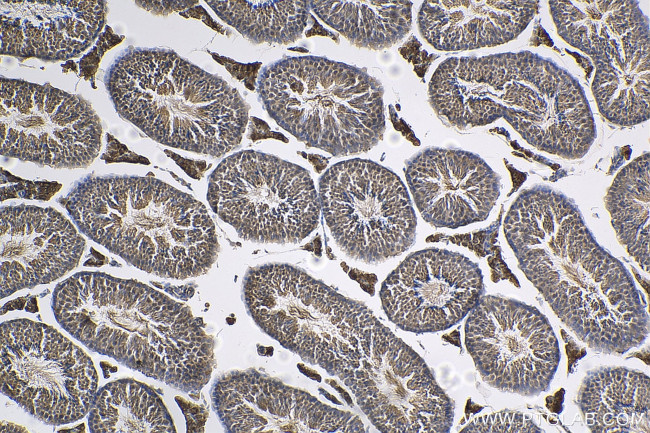
TEX15 Antibody in Immunohistochemistry (Paraffin) (IHC (P))
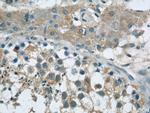
TEX15 Antibody in Immunohistochemistry (Paraffin) (IHC (P))

Search
Proteintech
TEX15 Polyclonal Antibody
{{$productOrderCtrl.translations['antibody.pdp.commerceCard.promotion.promotions']}}
{{$productOrderCtrl.translations['antibody.pdp.commerceCard.promotion.viewpromo']}}
{{$productOrderCtrl.translations['antibody.pdp.commerceCard.promotion.promocode']}}: {{promo.promoCode}} {{promo.promoTitle}} {{promo.promoDescription}}. {{$productOrderCtrl.translations['antibody.pdp.commerceCard.promotion.learnmore']}}
产品信息
24585-1-AP
种属反应
宿主/亚型
分类
类型
抗原
偶联物
形式
浓度
规格
纯化类型
保存液
内含物
保存条件
运输条件
产品详细信息
Immunogen sequence: MPSDAKDSV NGDLLLNWTS LKNILSGLNA SFPLHNNTGS STVTTSKSIK DPRLMRREES MGEQSSTAGL NEVLQFEKSS DNVNSEIKST PSNSASSS (1-97 aa encoded by BC141841)
靶标信息
Required during spermatogenesis for normal chromosome synapsis and meiotic recombination in germ cells. Necessary for formation of DMC1 and RAD51 foci on meiotic chromosomes, suggesting a specific role in DNA double-stranded break repair.
仅用于科研。不用于诊断过程。未经明确授权不得转售。
生物信息学
蛋白别名: cancer/testis antigen 42; testis expressed gene 15; Testis-expressed protein 15; testis-expressed sequence 15 protein
基因别名: 2210014E14Rik; AL022622; AU022940; CT42; SPGF25; Tex15
UniProt ID: (Mouse) F8VPN2
Entrez Gene ID: (Human) 56154, (Mouse) 104271, (Rat) 290803